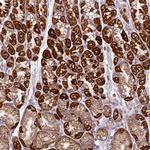
MT-CO2 Antibody in Immunohistochemistry (Paraffin) (IHC (P))

Search
Invitrogen
MT-CO2 Polyclonal Antibody
{{$productOrderCtrl.translations['antibody.pdp.commerceCard.promotion.promotions']}}
{{$productOrderCtrl.translations['antibody.pdp.commerceCard.promotion.viewpromo']}}
{{$productOrderCtrl.translations['antibody.pdp.commerceCard.promotion.promocode']}}: {{promo.promoCode}} {{promo.promoTitle}} {{promo.promoDescription}}. {{$productOrderCtrl.translations['antibody.pdp.commerceCard.promotion.learnmore']}}
产品信息
PA5-84218
种属反应
宿主/亚型
分类
类型
抗原
偶联物
形式
浓度
规格
纯化类型
保存液
内含物
保存条件
运输条件
RRID
产品详细信息
Immunogen sequence: YEYTDYGGLI FNSYILPPLF LEPGDLRLLD VDNRVVLPIE APIRIIITS
Highest antigen sequence indentity to the following orthologs: Mouse - 65%, Rat - 65%.
靶标信息
Component of the cytochrome c oxidase, the last enzyme in the mitochondrial electron transport chain which drives oxidative phosphorylation. The respiratory chain contains 3 multisubunit complexes succinate dehydrogenase (complex II, CII), ubiquinol-cytochrome c oxidoreductase (cytochrome b-c1 complex, complex III, CIII) and cytochrome c oxidase (complex IV, CIV), that cooperate to transfer electrons derived from NADH and succinate to molecular oxygen, creating an electrochemical gradient over the inner membrane that drives transmembrane transport and the ATP synthase. Cytochrome c oxidase is the component of the respiratory chain that catalyzes the reduction of oxygen to water. Electrons originating from reduced cytochrome c in the intermembrane space (IMS) are transferred via the dinuclear copper A center (CU(A)) of subunit 2 and heme A of subunit 1 to the active site in subunit 1, a binuclear center (BNC) formed by heme A3 and copper B (CU(B)). The BNC reduces molecular oxygen to 2 water molecules using 4 electrons from cytochrome c in the IMS and 4 protons from the mitochondrial matrix. [UniProt]
仅用于科研。不用于诊断过程。未经明确授权不得转售。
篇参考文献 (0)
生物信息学
蛋白别名: Co2; cyclooxygenase